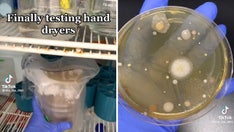
Woman's viral TikTok reveals how much bacteria live in public bathroom hand dryers: 'Trigger warning'

Fox News Flash top headlines for August 22
Fox News Flash top headlines are here. Check out what's clicking on Foxnews.com.
Inquiring minds on social media want to know if homeowners and renters enforce a shoes-off policy for guests as people debate how hygienic the household rule really is, and whether it can create awkward social blunders.
The question has been asked on Facebook, Instagram, Twitter, TikTok and YouTube, with photos and videos generating millions of views and thousands of comments from users who seem to have strong feelings on the topic.
In public forums, people who side with taking shoes off before entering a home say they think it’s unsanitary to wear outdoor shoes inside.
On the flip side, people who side with keeping shoes on when entering home say they think it’s unsanitary and unsightly to have bare or shoeless feet exposed.

When visiting the home of a family member, friend or colleague, guests should remember that some households have a "no outside shoes inside" rule. (iStock)
Here’s what cleaning professionals and etiquette experts have to say about the subject, and practical advice for hosts and guests.
Shoes on or off? Hosts are free to make the rules
Regardless of where one might land on the shoes inside homes debate, etiquette and event experts agree that hosts can make and enforce shoes-off rules for visitors the same way they do for family members.
Mariah Grumet, a certified etiquette trainer and the founder of Old Soul Etiquette LLC, an etiquette school in New York City, told Fox News Digital that hosts may have a cultural or religious reason for wanting shoes removed before entering a home.
"From the guest’s perspective, it’s important to respect your host’s wishes," she said.
Hosts who are having guests over for the first time might want to give advance notice, so guests have an opportunity to bring "indoor-only shoes or socks" if walking barefoot is something they’re not comfortable with, according to Grumet.
ARE YOU WASHING YOUR BATH TOWELS ENOUGH? HERE'S WHAT EXPERTS HAVE TO SAY
"You may also want to consider having a clean slipper or sock collection to offer your guests when they are removing their shoes," Grumet went on. "As a host, you want to make sure your guests are as comfortable as possible."

Having extra slippers and socks for guests can provide comfort in case visitors have issues or concerns about walking barefoot. (iStock)
Asking guests to take off their shoes before they enter a home doesn’t have to be an awkward interaction either, Grumet said.
Hosts can nicely word their request by saying, "Would you be so kind to remove your shoes?" Grumet added.
Guests who need to wear shoes indoors "for medical or other reasons" can also ask a host if they have a no-shoes inside rule before they pencil in a visit, so plans can be made accordingly, said Grumet.
"This is a win-win, so you are able to respect your host’s wishes without compromising your safety or comfort," she said.
VIRAL HOUSE CLEANING VIDEOS ARE SATISFYING BILLIONS ON TIKTOK
Hosts may not be obligated to give reasons
Meredith Corning, of Bentonville, Arkansas, owner and lead planner at Meredith Events, which serves clients in the Ozark Mountains region, told Fox News Digital that hosts shouldn’t be afraid to ask guests to take off their shoes before entering their home.
"It is perfectly acceptable," she said. "Many cultures have done this for centuries."

Hosts should make sure they greet guests before asking them to take off shoes, etiquette and event experts say. (iStock)
At the same time, Corning warns that hosts shouldn’t forget to give their guests a "warm hello" before they issue a request.
Hosts can make shoe removal practices a "welcoming experience" by stocking entryways with unopened spa slippers and seating if space allows for it, Corning said.
Doing this gets the point across "without sounding like an overbearing schoolmarm," she continued.
TIKTOKERS ARE SHARING 'WEDDING RULES' THEY WANT GUESTS TO FOLLOW
Corning said hosts don’t necessarily have to explain why they have a no-shoes household rule, but having an answer in case someone asks can smooth over any awkwardness.
Hosts can say, according to Corning, "I know it may seem over the top, but that’s what we do here to keep the floors clean."
Or if children are living at the home, hosts can say, "We had to create this rule because the kids will track in such a mess if we do not. If it’s a rule for them, then it’s only fair that it becomes a rule for everyone to stay consistent."

Parents and guardians can let guests know if their home has a "no shoes inside" rule if tracking dirt is a major concern, etiquette experts say. (iStock)
Hosts might even want to consider buying an "adorable sign" that can subtly inform or remind guests of their no-shoes inside rule, Corning said.
How often should floors be cleaned?
Toby Schulz, the co-founder and CEO of Maid2Match, an Australian house cleaning service, told Fox News Digital that wearing outdoor footwear inside can bring "germs and dirt" into homes.
FOLLOW US ON FACEBOOK FOR MORE FOX LIFESTYLE NEWS
"To help counter this, sweep or vacuum once a day to prevent the accumulation of dirt and dust," he said. "Then wet-mop the floors in high-traffic areas once a week."
A microbiology study published by the University of Arizona found that shoe soles have 421,000 units of bacteria on average while shoe interiors have 2,887 units of bacteria on average, which includes bacteria E. Coli, Klebsiella pneumonia and Serratia ficaria.
Additional studies in recent years from the Journal of Applied Microbiology and the International Journal of Environmental Research and Public Health, which are available for viewing on the National Library of Medicine's website, have found that shoe soles are potential vectors for infectious disease because they contain multidrug-resistant microbes.

Floors should be mopped weekly and swept or vacuumed daily, cleaning experts say. (iStock)
Bacteria and dirt transfer can be minimized when shoe wearers remove their outdoor footwear before entering a home, according to Schulz.
He recommends hosts set up an entryway shoe rack or cabinet to store outdoor shoes and keep them from dirtying floors.
CLICK HERE TO SIGN UP FOR OUR LIFESTYLE NEWSLETTER
House slippers or sandals can be stashed in shoe storage furniture or private areas like bedrooms and bathrooms, Schulz added.
If asking a guest to remove shoes seems like too much of a hassle, Schulz said guests can place floor mats in entryways, so visitors can clean their shoes before stepping in.
Shoes off seems to be more common now
Laura Windsor, founder of the Laura Windsor Etiquette Academy in London, England, told Fox News Digital guests shouldn’t be shocked if a host asks them to take shoes off before entering their home.
"More and more people are preferring to take their shoes off at home, so it is by no means a strange concept," she said.

Having shoe racks near entryways can keep outside shoes contained in one area, according to cleaning and etiquette experts. Microbiology studies say shoe soles carry disease-carrying bacteria. (iStock)
"If you are a guest, you are entering someone else’s ‘sanctuary,’ so you should respect a host’s wishes and happily follow their house rules," Windsor continued. "It would be ungracious for a guest to refuse such a request."
CLICK HERE TO GET THE FOX NEWS APP
Embarrassing moments – such as having smelly, torn or inside-out socks – can hopefully be avoided if a host provides advance notice, Windsor said.
A 2018 lifestyle poll published by the market research firm YouGov found that 87% of Americans reportedly take their shoes off before entering their own home, but only half of those who do ask their guests to do the same.